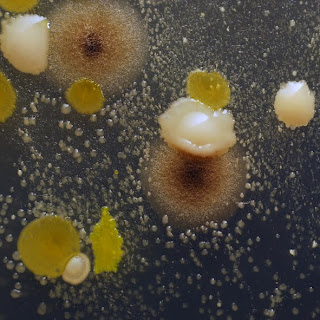

Interacción, análisis y registro de las
criaturas invisibles (microscópicas) que habitan en el río Paraná (agua y
tierra de la costa e Isla- Rosario).
Año de inicio 2019
Río Paraná. Fotografía digital. Tamaño
variable.
Muestra
N°2, Registro de Microbestias. 20 dibujos- fibra sobre papel (16x21cm), vidrios
y soporte plástico. 2020
Muestra N°2, Arreglos de Microbestias. Instalación. 3
dibujos- fibra sobre papel (41x35cm y 2 de 15,5x24cm), frasco de vidrio con
parte de la Muestra N°2 (4 cm de diámetro y 13 cm de alto, sellado
herméticamente y rotulado- tierra de la isla y agua del Río Paraná- muestra
tomada el 3-8-2019).
Muestra N°1, Arreglos de Microbestias. Instalación. 2
dibujos- fibra sobre papel (15,5x24cm y 15,5x22cm), frasco de vidrio con parte
de la Muestra N°1 (4 cm de diámetro y 13 cm de alto, sellado herméticamente y
rotulado- tierra de la isla y agua del Río Paraná- muestra tomada el 27-7-2019).
Fichero-
Registro correspondiente a las Muestras 1,2,3 y 4. Fichas con datos (7,6 cm x
12,7 cm) y fichero metálico. 2020
Biogeneradores de microbestias. Instalación biogeneradores conteniendo muestras que no interaccionarán naturalmente (por razones ambientales, de tiempo y/o espacio). 2022
Registro de Microbestias. Fibra sobre papel 2020 a 2022
Acción colectiva. 2022
Técnica mixta. Lienzo intervenido por los microorganismos del Paraná y posterior registro con grafito.
200x150 cm.
-Etapa I: acción de los microorganismos (microbestias) habitantes de las Islas del Paraná (tela enterrada el 02-08-2022 en la zona del Embudo, registro en ig @luciana.paoletti)
-Etapa II: estudio y registro de los microorganismos participantes (dibujo en grafito sobre el mismo lienzo).